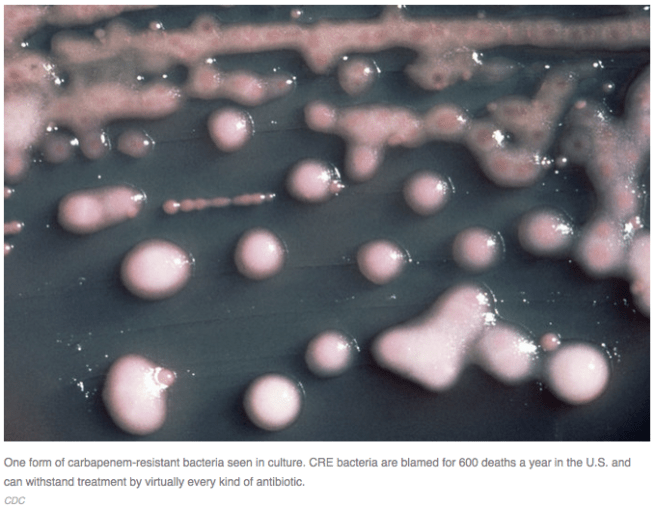
Screen Shot 2015-02-21 at 9.03.57 AM

The case of carbapenem resistant Enterobacteriaceae at UCLA
It is rare that a news story encapsulates three of my major interests in evolution and disease. The evolution of resistance to antimicrobials is a recurring theme on this blog. So is the importance of human-microbiome co-evolution. I am also interested in curbing the problem of overtreatment and overdiagnosis, using evolutionary principles to predict when treatments do more harm than good.
In case you didn’t hear about it, NPR yesterday ran a story about the risk of spreading carbapenem resistant Enterobacteriaceae (CRE) with endoscopes at UCLA. At least 100 people were exposed to this bacterium which can inhabit the tip of small flexible endoscopes used to visualize the pancreas and biliary tract. This procedure, called endoscopic retrograde cholagiopancreatography or ERCP for short, has been largely supplanted by an MRI version, MRCP, that does not involve the potential for complications by contaminated endoscopes. ERCP may be an unnecessary procedure in some patients.
This story also highlights the likelihood that using scopes that cannot be completely sterilized permits the evolution of highly virulent and resistant bacteria in a older, more fragile, population of patients. As Paul Ewald pointed out over 20 years ago, medical attendants can act as vectors for disease, enabling the evolution of hard-to-treat and virulent microbes. Just to be clear, when writers refer to the spread or development of resistance, they are really talking about the evolution of resistance. Words matter. Read this recent profile of researcher Andrew Read for an excellent and more extensive treatment of this topic.
The NPR story also mentioned the fact that these CRE bacteria can inhabit the microbiome without causing disease. Before you take a big sigh of relief, consider that CRE in the microbiome can cause havoc if a patient subsequently gets sick and receives antibiotics. Enterobacteriaceae are among the remaining microbes in the microbiome after antibiotic treatment, as shown by a recent paper on ICU patients by Zaborin and colleagues. CRE would have a huge selective advantage if the most powerful last-resort antibiotics like carbapenems are used. Resistant bacteria then can become invasive and deadly, especially when helpful commensal bacteria are killed by antibiotic treatment in the gut. Instead of harmless bystanders in the microbiome, CRE under those conditions are likely to cause fatal bloodstream infections.
Read the UCLA press report here.
Categories: Uncategorized
Joe Alcock
Emergency Physician, Educator, Researcher, interested in the microbiome, evolution, and medicine
5 replies ›